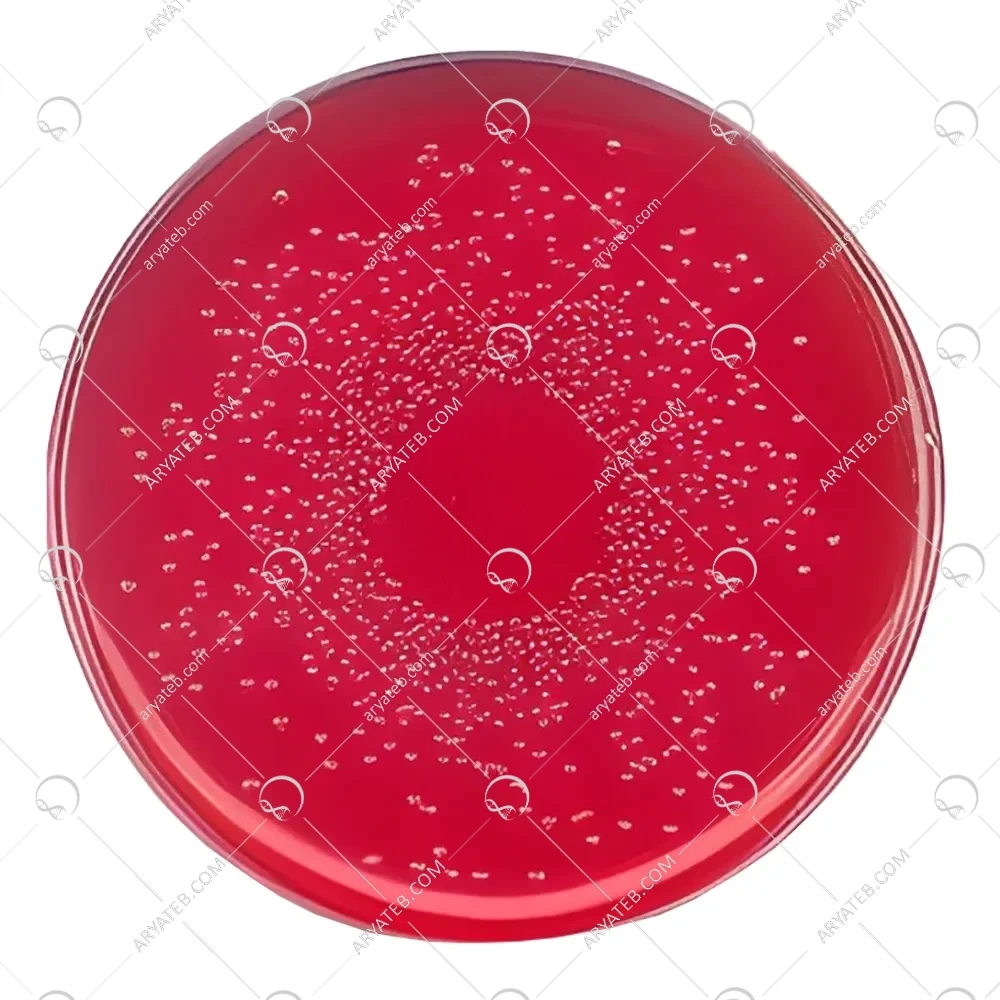

محیط کشت برلیانت گرین فنول رد لاکتوز ساکارز آگار
آگار سبز برلیانت فنل قرمز را به عنوان یک آگار انتخابی و تشخیصی برای جداسازی، به دنبال غنیسازی و غنیسازی انتخابی، سالمونلاهای غیر از سالمونلا تیفی از غذاها و خوراکها توصیف میکند. این فرمول که از هلند سرچشمه می گیرد، به طور گسترده در اروپا ارزیابی شده است. در روش استاندارد جامعه اروپا و در استانداردهای سازمان بین المللی استاندارد استفاده می شود. آگار سبز برلیانت فنل قرمز از عصاره گوشت، پپتون، عصاره مخمر، دی سدیم هیدروژن ارتو فسفات، سدیم دی هیدروژن ارتو فسفات، لاکتوز، ساکارز، فنل قرمز، سبز درخشان، آگار و آب مقطر یا دیونیزه تشکیل شده است.
ویژگی های محیط کشت برلیانت گرین فنول رد لاکتوز ساکارز
در شرایط آسپتیک، 1 میلی لیتر محلول سبز درخشان به محلول شکر/فنل قرمز که تا حدود 55 درجه سانتیگراد سرد شده است، اضافه می شود. مقادیر حدود 40 میلی لیتر از محیط تازه تهیه شده توزیع می شود و تا دمای 45 درجه سانتیگراد در ظروف پتری استریل به قطر 14 سانتی متر سرد می شود. اگر ظروف بزرگ در دسترس نبود، حدود 15 میلی لیتر در ظروف پتری با قطر 9 سانتی متر بریزید. کلنی های معمولی گونه های سالمونلا. عمدتا صاف، محدب بسیار کم و صورتی/قرمز مرطوب هستند. ارزیابی کیفیت بر اساس بهره وری، انتخاب پذیری و ظاهر مشخصه کلنی ها انجام می شود. ترکیب پپتون، تریپتون و عصاره مخمر باعث می شود که محیط بسیار مغذی باشد. آمینو اسیدها و زنجیره های بلند پپتیدها را تامین می کند. کلرید سدیم مسئول تعادل اسمزی است. لاکتوز و ساکارز هر دو منابع کربوهیدرات قابل تخمیر هستند. فنل قرمز یک شاخص اسید-باز است. رنگ زرد را به باکتری های تخمیر کننده لاکتوز و یا ساکارز می دهد. سبز درخشان محیط رشد اکثر باکتری های گرم منفی و گرم مثبت را مهار می کند و به سالمونلاها کمک می کند. میکروبهایی مانند سالمونلا تیفی، گونههای شیگلا، اشریشیا کلی، گونههای سودوموناس، گونههای پروتئوس و استافیلوکوکوس اورئوس عمدتاً ساکن هستند. باکتری های تخمیر کننده غیر لاکتوز طی 24-18 ساعت پس از انکوباسیون، کلنی های سفید تا صورتی متمایل به قرمز را نشان می دهند. گونه های سالمونلا تیفی و شیگلا ممکن است در این محیط رشد نکنند. با این حال، گونه های پروتئوس، سودوموناس و سیتروباکتر ممکن است با ایجاد کلنی های قرمز کوچک، پاتوژن های روده ای را تقلید کنند.
خرید محیط کشت برلیانت گرین فنول قرمز لاکتوز ساکارز آگار (BPLS)
آریا طب یک شرکت فعال در زمینه فروش انواع محصولات آزمایشگاهی و محیط های کشت مرغوب می باشد. فروش مدیوم مکعبی برلیانت گرین فنول رد لاکتوز ساکارز آگار با کیفیت بالا و قیمت مناسب در فروشگاه آریا طب انجام می شود. پس از ثبت و نهایی شدن سفارش شما، محیط کشت برلیانت گرین فنول رد لاکتوز ساکارز آگار مکعب از طریق پیک در تهران و یا پست پیشتاز در شهرستان ها ارسال می شود.
محیط کشت برلیانت سبز فنول رد لاکتوز ساکارز آگار (BPLS) یکی از محیط های کشت موجود در فروشگاه آریا طب می باشد. این محیط کشت برای جداسازی سالمونلا از فرآورده های گوشتی و سایر مواد غذایی است. محیط کشت برلیانت گرین فنول رد ساکارز آگار محیطی مناسب برای رشد باکتری های گرم مثبت است.
خصوصیات محیط کشت برلیانت گرین فنل قرمز لاکتوز ساکارز آگار (BPLS)
- حاوی فنل قرمز برای نشان دادن اسیدی شدن محیط با تغییر رنگ آن از قرمز به زرد
- محیط کشت انتخابی
- سبز درخشان در محیط برای جلوگیری از رشد باکتری های گرم مثبت مانند شیگلا
استفاده از محیط کشت برلیانت سبز فنل قرمز لاکتوز ساکارز آگار (BPLS)
- مناسب برای شناسایی سالمونلا، کلبسیلا، پروتئوس ولگاریس و...
فروشگاه اینترنتی آریا طب انواع محیط های کشت پرکاربرد در آزمایشگاه های تحقیقاتی و مراکز آموزشی را به صورت آنلاین به فروش می رساند. برای خرید محیط کشت مکعبی ساکارز آگار لاکتوز برلیانت سبز فنول قرمز لاکتوز می توانید سفارش خود را در این صفحه ثبت کنید. محیط کشت برلیانت گرین فنول قرمز لاکتوز ساکارز آگار مکعب با پیک در تهران و یا پست پیشتاز در شهرستان ها ارسال می شود. در صورت نیاز به اطلاعات بیشتر با واحد پشتیبانی آریا طب تماس بگیرید.
کاربرد های محیط کشت برلیانت گرین فنول رد لاکتوز ساکارز
برلیانت گرین آگار برای انتخاب و تمایز سالمونلا (به غیر از S. typhi) از غذاها یا مواد خوراکی استفاده می شود. برلیانت گرین آگار برای استفاده در تشخیص بیماری یا سایر شرایط در انسان در نظر گرفته نشده است. اولین بار توسط کریستنسن و همکاران در سال 1925 به عنوان یک محیط انتخابی برای جداسازی سالمونلا (به جز S. typhi) معرفی شد. این رسانه توسط موسسه بهداشت عمومی هلند، اوترخت اصلاح شد. اصلاح برای افزایش گزینش پذیری محیط با افزایش غلظت رنگ بود. این فرمول توسط سازمان استاندارد بین المللی، روش های استاندارد جامعه اروپایی، انجمن بهداشت عمومی آمریکا و انجمن شیمیدانان رسمی تحلیلی نقل شده است. این محیط برای خرده فرهنگ های از محیط های غنی سازی انتخابی مناسب است. با این حال، از آنجایی که این محیط بسیار انتخابی است، ممکن است تعداد کمی از سالمونلاها نادیده گرفته شوند. این محیط برای S. typhi و Shigella spp توصیه نمی شود. محیط های بازدارنده کمتر مانند X.L.D. (NCM0021) و Hektoen Enteric Agar (NCM0006) در تشخیص سالمونلا تیفی و شیگلا spp مفید خواهند بود. که توسط برلیانت گرین آگار مهار میشوند.
آدرس ایمیل شما منتشر نخواهد شد. فیلدهای الزامی علامت گذاری شده اند *